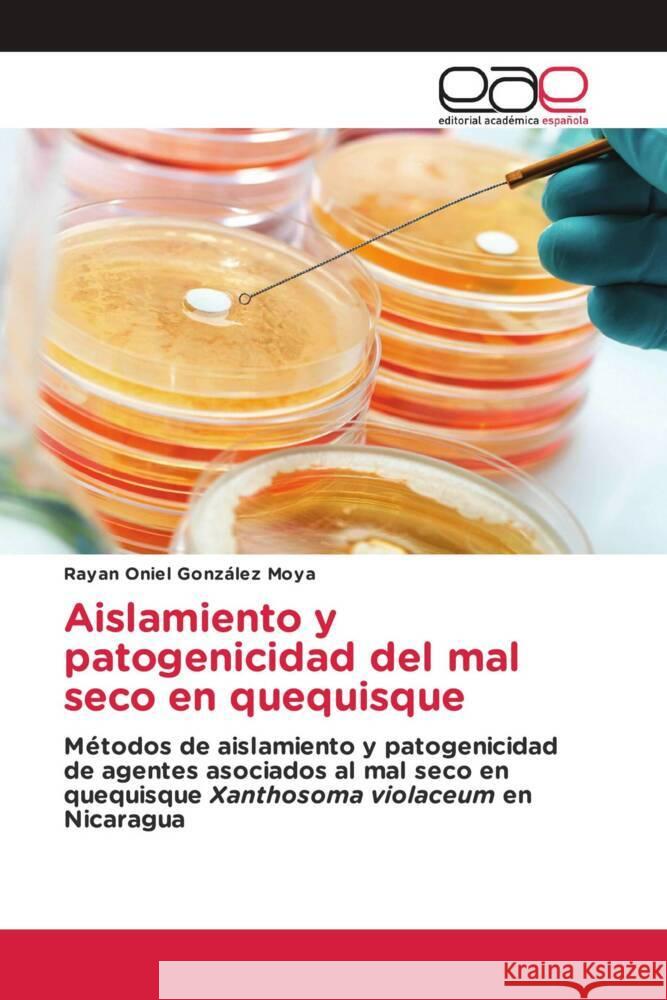
Aislamiento y patogenicidad del mal seco en quequisque
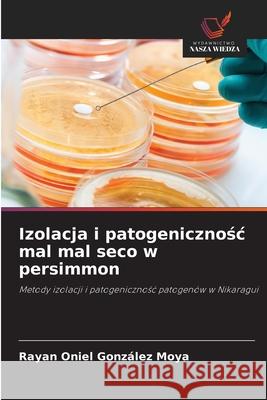
Izolacja i patogenicznosc mal mal seco w persimmon
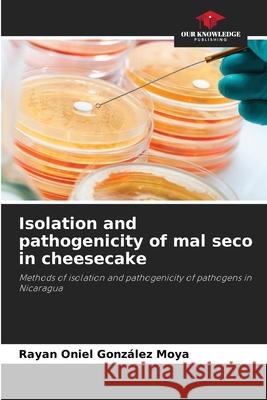
Isolation and pathogenicity of mal seco in cheesecake
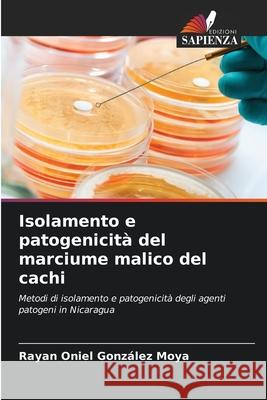
Isolamento e patogenicità del marciume malico del cachi

topmenu
Gonzalez, Ray
Ray Gonzalez received his MFA in creative writing from Texas State University and is a professor in the English Department and Creative Writing Program at the University of Minnesota. He is the author of ten books of poetry including Faith Run (University of Arizona Press, 2009); Cool Auditor: Prose Poems (BOA Editions, 2009); The Religion of Hands (2005), which received the 2006 Latino Heritage Award for Best Book of Poetry; The Hawk Temple at Tierra Grande Poems (2002), a winner of a 2003 Minnesota Book Award; Turtle Pictures (2000), a winner of a 2001 Minnesota Book Award; and The Heat of A...